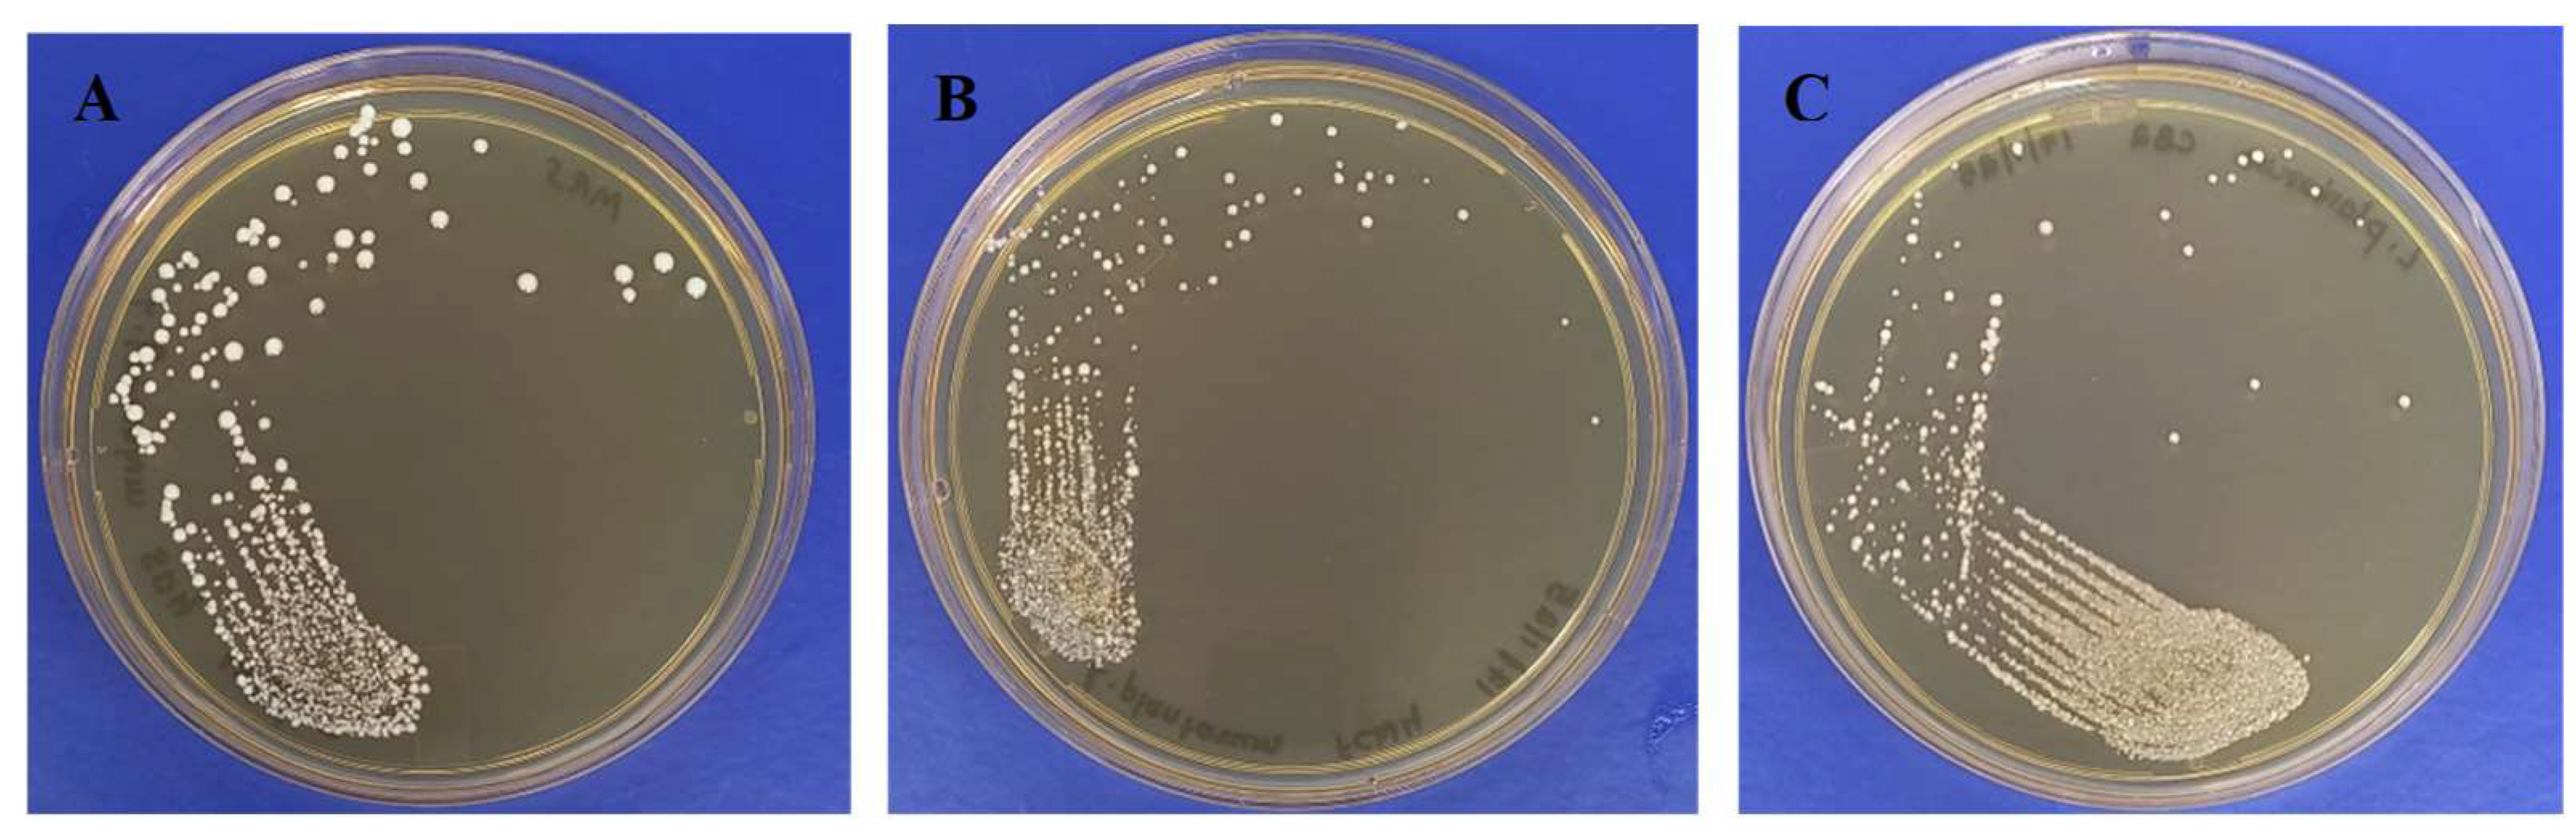
Toxins 17 00068 g002
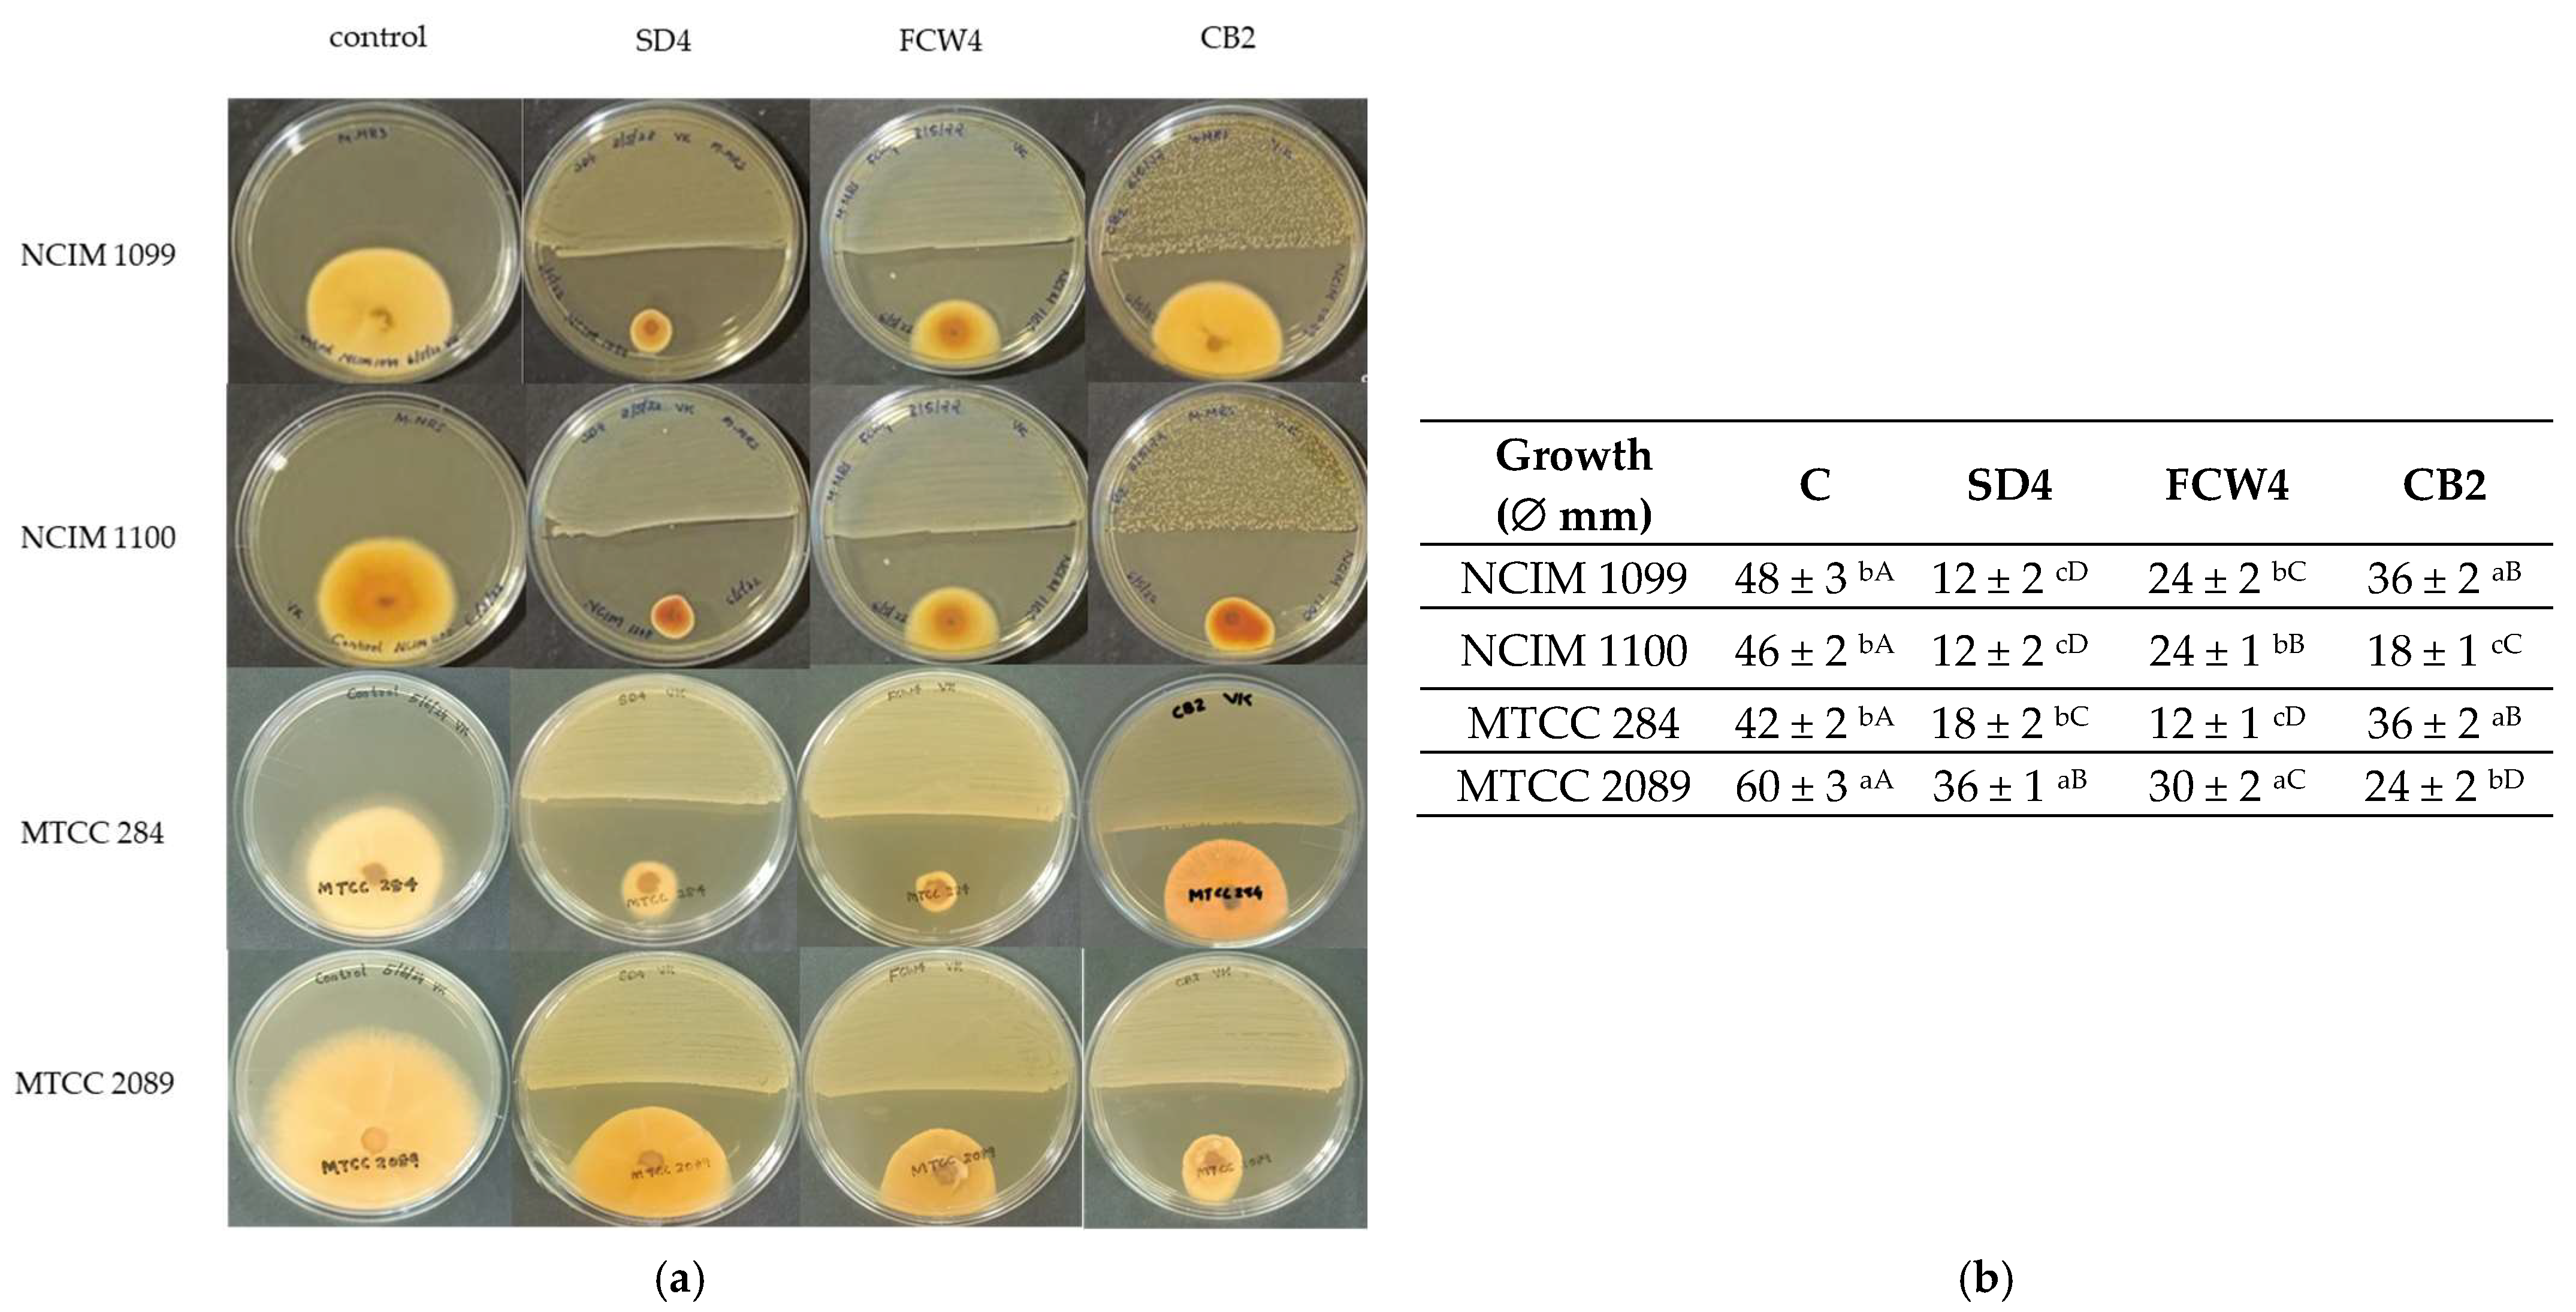
Toxins 17 00068 g003

Biocontrol Activity of New Lactic Acid Bacteria Isolates Against Fusaria and Fusarium Mycotoxins
Abstract
1. Introduction
2. Results
2.1. Characterization of LABs Capable of Fusarium Antagonism
2.2. Characterization of Fusarium Antagonism
2.3. Resistance to Mycotoxins and Mycotoxin Reduction
2.4. Biocontrol Against Fusaria on Seeds and Crops
2.4.1. Antifungal Effect on Peanut
2.4.2. Antifungal Effect on Wheat
2.4.3. Corn Germination Test
2.4.4. Silage Fermentation
3. Discussion
4. Materials and Methods
4.1. Materials
4.2. Microorganisms
4.3. Characterization of Lactic Acid Bacteria
4.4. Molecular Identification
4.5. Antagonism Tests
4.6. Preparation of Bioactive Extracts and Disc Diffusion Assay
4.7. Mycotoxin Detection by HPLC
4.8. Fumonisin Detection in ELISA Assay
4.9. Microbiological Analysis
4.10. Mycotoxin Resistance
4.11. Mycotoxin Reduction Tests
4.12. Biocontrol Efficiency of the LAB Strains
4.12.1. Peanut
4.12.2. Wheat
4.12.3. Corn Germination Test
4.13. Forage Fermentation
4.14. Statistical Analysis
Author Contributions
Funding
Institutional Review Board Statement
Informed Consent Statement
Data Availability Statement
Acknowledgments
Conflicts of Interest
References
- Munkvold, G.P.; Proctor, R.H.; Moretti, A. Mycotoxin production in Fusarium according to contemporary species concepts. Ann. Rev. Phytopathol. 2021, 59, 373–402. [Google Scholar] [CrossRef] [PubMed]
- Perincherry, L.; Lalak-Kańczugowska, J.; Stępień, Ł. Fusarium-produced mycotoxins in plant-pathogen interactions. Toxins 2019, 11, 664. [Google Scholar] [CrossRef] [PubMed]
- Vipin Krishnan, S.; Nampoothiri, K.M.; Suresh, A.; Linh, N.T.; Balakumaran, P.A.; Pócsi, I.; Pusztahelyi, T. Fusarium biocontrol: Antagonism and mycotoxin elimination by lactic acid bacteria. Front. Microbiol. 2024, 14, 1260166. [Google Scholar] [CrossRef] [PubMed]
- Kamle, M.; Mahato, D.K.; Devi, S.; Lee, K.E.; Kang, S.G.; Kumar, P. Fumonisins: Impact on agriculture, food, and human health and their management strategies. Toxins 2019, 11, 328. [Google Scholar] [CrossRef] [PubMed]
- Hao, G.; McCormick, S.; Usgaard, T.; Tiley, H.; Vaughan, M.M. Characterization of three Fusarium graminearum effectors and their roles during Fusarium head blight. Front. Plant Sci. 2020, 11, 579553. [Google Scholar] [CrossRef]
- López-Berges, M.S.; Hera, C.; Sulyok, M.; Schäfer, K.; Capilla, J.; Guarro, J.; Di Pietro, A. The velvet complex governs mycotoxin production and virulence of Fusarium oxysporum on plant and mammalian hosts. Mol. Microbiol. 2013, 87, 49–65. [Google Scholar] [CrossRef]
- Bangar, S.P.; Chaudhary, V.; Singh, T.P.; Özogul, F. Retrospecting the concept and industrial significance of LAB bacteriocins. Food Biosci. 2022, 46, 101607. [Google Scholar] [CrossRef]
- Sadiq, F.A.; Yan, B.; Tian, F.; Zhao, J.; Zhang, H.; Chen, W. Lactic acid bacteria as antifungal and anti-mycotoxigenic agents: A comprehensive review. Comp. Rev. Food Sci. Food Saf. 2019, 18, 1403–1436. [Google Scholar] [CrossRef]
- Salman, M.; Javed, M.R.; Ali, H.; Mustafa, G.; Tariq, A.; Sahar, T.; Naheed, S.; Gill, I.; Abid, M.; Tawab, A. Bioprotection of Zea mays L. from aflatoxigenic Aspergillus flavus by Loigolactobacillus coryniformis BCH-4. PLoS ONE 2022, 17, e0271269. [Google Scholar] [CrossRef] [PubMed]
- Yépez, A.; Luz, C.; Meca, G.; Vignolo, G.; Mañes, J.; Aznar, R. Biopreservation potential of lactic acid bacteria from Andean fermented food of vegetal origin. Food Cont. 2017, 78, 393–400. [Google Scholar] [CrossRef]
- Muhialdin, B.J.; Saari, N.; Meor Hussin, A.S. Review on the biological detoxification of mycotoxins using lactic acid bacteria to enhance the sustainability of foods supply. Molecules 2020, 25, 2655. [Google Scholar] [CrossRef] [PubMed]
- Nasrollahzadeh, A.; Mokhtari, S.; Khomeiri, M.; Saris, P. Mycotoxin detoxification of food by lactic acid bacteria. Int. J. Food Cont. 2022, 9, 1–9. [Google Scholar] [CrossRef]
- Smaoui, S.; Agriopoulou, S.; D’Amore, T.; Tavares, L.; Mousavi Khaneghah, A. The control of Fusarium growth and decontamination of produced mycotoxins by lactic acid bacteria. Crit. Rev. Food Sci. Nutr. 2023, 63, 11125–11152. [Google Scholar] [CrossRef] [PubMed]
- Dalié, D.K.D.; Deschamps, A.M.; Richard-Forget, F. Lactic acid bacteria–Potential for control of mould growth and mycotoxins: A review. Food Cont. 2010, 21, 370–380. [Google Scholar] [CrossRef]
- Muhialdin, B.J.; Zaiton, H.; Sajaa, K.S.; Nur Aqilah, Z.; Azfar, A.A. Effect of pH and heat treatment on antifungal activity of Lactobacillus fermentum Te007, Lactobacillus pentosus G004 and Pediococcus pentosaceus Te010. Inn. Rom. Food Biotec. 2011, 8, 41–43. [Google Scholar]
- Garcia, M.V.; Stefanello, R.F.; Pia, A.K.; Lemos, J.G.; Nabeshima, E.H.; Bartkiene, E.; Rocha, J.M.; Copetti, M.V.; Sant’Ana, A.S. Influence of Limosilactobacillus fermentum IAL 4541 and Wickerhamomyces anomalus IAL 4533 on the growth of spoilage fungi in bakery products. Int. J. Food Microbiol. 2024, 413, 110590. [Google Scholar] [CrossRef]
- Mandal, S.; Mandal, N.C. Formulation of food grade Limosilactobacillus fermentum for antifungal properties isolated from home-made curd. Sci. Rep. 2023, 13, 20371. [Google Scholar] [CrossRef] [PubMed]
- Ogunremi, O.R.; Leischtfeld, S.F.; Mischler, S.; Schwenninger, S.M. Antifungal activity of lactic acid bacteria isolated from kunu-zaki, a cereal-based Nigerian fermented beverage. Food Biosci. 2022, 49, 101648. [Google Scholar] [CrossRef]
- Vanitha, P.R.; Shivakumar, D.; Basavaraj, S.; Gunduraj, A.; Janardanachar, D.; BV, D.; Yanjarappa Sreenivasa, M. Limosilactobacillus fermentum MYSY8, a potential probiotic isolate from fermented rice beverage for the control of Microsporum canis. Food Biotech. 2024, 38, 314–342. [Google Scholar] [CrossRef]
- Gerez, C.L.; Torino, M.I.; Rollán, G.; de Valdez, G.F. Prevention of bread mould spoilage by using lactic acid bacteria with antifungal properties. Food Cont. 2009, 20, 144–148. [Google Scholar] [CrossRef]
- Mahjoory, Y.; Mohammadi, R.; Hejazi, M.A.; Nami, Y. Antifungal activity of potential probiotic Limosilactobacillus fermentum strains and their role against toxigenic aflatoxin-producing aspergilli. Sci. Rep. 2023, 13, 388. [Google Scholar] [CrossRef] [PubMed]
- Harčárová, M.; Čonková, E.; Nad, P.; Váczi, P.; Proškovcová, M. Inhibitory activity of cell-free supernatants of Lactobacillus spp. and Bacillus spp. against Fusarium Graminearum. Folia Vet. 2021, 65, 9–14. [Google Scholar] [CrossRef]
- Adithi, G.; Divyashree, S.; Shruthi, B.; Deepa, N.; Sreenivasa, M.Y. Evaluation of Limosilactobacillus fermentum MYSAGAM1 isolated from herbal Amla juice as a probiotic candidate with antifungal characteristics against Fusarium equiseti. Food Biosci. 2024, 58, 103843. [Google Scholar] [CrossRef]
- Kim, J.H.; Lee, E.S.; Kim, B.M.; Ham, J.S.; Oh, M.H. Broad-spectrum antimicrobial activity of cinnamoyl esterase-producing Lactobacilli and their application in fermented rice bran. J. Sci. Food Agric. 2022, 102, 3130–3139. [Google Scholar] [CrossRef] [PubMed]
- De Muynck, C.; Leroy, A.I.; De Maeseneire, S.; Arnaut, F.; Soetaert, W.; Vandamme, E.J. Potential of selected lactic acid bacteria to produce food compatible antifungal metabolites. Microbiol. Res. 2004, 159, 339–346. [Google Scholar] [CrossRef] [PubMed]
- Magnusson, J.; Ström, K.; Roos, S.; Sjögren, J.; Schnürer, J. Broad and complex antifungal activity among environmental isolates of lactic acid bacteria. FEMS Microbiol. Lett. 2003, 219, 129–135. [Google Scholar] [CrossRef] [PubMed]
- Laitila, A.; Alakomi, H.L.; Raaska, L.; Mattila-Sandholm, T.; Haikara, A. Antifungal activities of two Lactobacillus plantarum strains against Fusarium moulds in vitro and in malting of barley. J. Appl. Microbiol. 2002, 93, 566–576. [Google Scholar] [CrossRef] [PubMed]
- Lowe, D.P.; Ulmer, H.M.; Graser, K.; Arendt, E.K. The influence of starter cultures on barley contaminated with Fusarium culmorum TMW 4.0754. J. Am. Soc. Brew. Chem. 2006, 64, 158–165. [Google Scholar] [CrossRef]
- Sathe, S.J.; Nawani, N.N.; Dhakephalkar, P.K.; Kapadnis, B. Antifungal lactic acid bacteria with potential to prolong shelf-life of fresh vegetables. J. Appl. Microbiol. 2007, 103, 2622–2628. [Google Scholar] [CrossRef]
- Higa, T.; Parr, J.F. Beneficial and Effective Microorganisms for a Sustainable Agriculture and Environment; International Nature Farming Research Center: Atami, Japan, 1994; pp. 1–16. [Google Scholar]
- Oliveira, P.M.; Zannini, E.; Arendt, E.K. Cereal fungal infection, mycotoxins, and lactic acid bacteria mediated bioprotection: From crop farming to cereal products. Food Microbiol. 2014, 37, 78–95. [Google Scholar] [CrossRef] [PubMed]
- Šaric, G.K.; Rapcan, I.; Potoènik, I.; Sarajlic, A.; Majić, I. Potential of lactic acid bacteria in biocontrol of Aspergillus niger, Penicillium chrysogenum and Fusarium graminearum in culture media and natural substrate. Zemdirb.-Agric. 2021, 108, 153–158. [Google Scholar] [CrossRef]
- Kim, D.H.; Lee, K.D.; Choi, K.C. Role of LAB in silage fermentation: Effect on nutritional quality and organic acid production—An overview. AIMS Agric. Food 2021, 6, 216–234. [Google Scholar] [CrossRef]
- Yuan, X.; Yang, X.; Wang, W.; Li, J.; Dong, Z.; Zhao, J.; Shao, T. The effects of natamycin and hexanoic acid on the bacterial community, mycotoxins concentrations, fermentation profiles, and aerobic stability of high moisture whole-crop corn silage. Anim. Feed. Sci. Techn. 2022, 286, 115250. [Google Scholar] [CrossRef]
- Kharazian, Z.A.; Jouzani, G.S.; Aghdasi, M.; Khorvash, M.; Zamani, M.; Mohammadzadeh, H. Biocontrol potential of Lactobacillus strains isolated from corn silages against some plant pathogenic fungi. Biol. Cont. 2017, 110, 33–43. [Google Scholar] [CrossRef]
- Khubber, S.; Marti-Quijal, F.J.; Tomasevic, I.; Remize, F.; Barba, F.J. Lactic acid fermentation as a useful strategy to recover antimicrobial and antioxidant compounds from food and by-products. Curr. Opin. Food Sci. 2022, 43, 189–198. [Google Scholar] [CrossRef]
- Driehuis, F. Silage and the safety and quality of dairy foods: A review. Agric. Food Sci. 2013, 22, 16–34. [Google Scholar] [CrossRef]
- Nyamete, F.A.; Mourice, B.; Mugula, J.K. Fumonisin B1 reduction in lactic acid bacteria fermentation of maize porridges. Tanzan. J. Agric. Sci. 2016, 15, 13–20. [Google Scholar]
- Chlebicz, A.; Śliżewska, K. In vitro detoxification of aflatoxin B 1, deoxynivalenol, fumonisins, T-2 toxin and zearalenone by probiotic bacteria from genus Lactobacillus and Saccharomyces cerevisiae yeast. Probiot. Antimicrob. Prot. 2020, 12, 289–301. [Google Scholar] [CrossRef] [PubMed]
- Ogunade, I.M.; Martinez-Tuppia, C.; Queiroz, O.C.; Jiang, Y.; Drouin, P.; Wu, F.; Viyas, D.; Adesogan, A.T. Silage review: Mycotoxins in silage: Occurrence, effects, prevention, and mitigation. J. Dairy Sci. 2018, 101, 4034–4059. [Google Scholar] [CrossRef] [PubMed]
- Jensen, T.; de Boevre, M.; Preußke, N.; de Saeger, S.; Birr, T.; Verreet, J.; Sönnichsen, F. Evaluation of high-resolution mass spectrometry for the quantitative analysis of mycotoxins in complex feed matrices. Toxins 2019, 11, 531. [Google Scholar] [CrossRef]
- Keller, L.A.M.; Gonzáles Pereyra, M.L.; Keller, K.M.; Alonso, V.A.; Oliveira, A.A.; Almeida, T.X.; Barbosa, T.S.; Nunes, L.M.T.; Cavaglieri, L.R.; Rosa, C.A.R. Fungal and mycotoxins contamination in corn silage: Monitoring risk before and after fermentation. J. Stored Prod. Res. 2013, 52, 42–47. [Google Scholar] [CrossRef]
- Gonçalves, A.; Gkrillas, A.; Dorne, J.L.; Dall’Asta, C.; Palumbo, R.; Lima, N.; Battilani, P.; Venâncio, A.; Giorni, P. Pre-and postharvest strategies to minimize mycotoxin contamination in the rice food chain. Comp. Rev. Food Sci. Food Saf. 2019, 18, 441–454. [Google Scholar] [CrossRef] [PubMed]
- Paswan, M.; Adhikary, S.; Salama, H.H.; Rusu, A.V.; Zuorro, A.; Dholakiya, B.Z.; Trif, M.; Bhattacharya, S. Microbial synthesis of lactic acid from cotton stalk for polylactic acid production. Microorganisms 2023, 11, 1931. [Google Scholar] [CrossRef] [PubMed]
- Kim, E.; Yang, S.M.; Lim, B.; Park, S.H.; Rackerby, B.; Kim, H.Y. Design of PCR assays to specifically detect and identify 37 Lactobacillus species in a single 96-well plate. BMC Microbiol. 2020, 20, 96. [Google Scholar] [CrossRef] [PubMed]
- Benson, D.A.; Cavanaugh, M.; Clark, K.; Karsch-Mizrachi, I.; Lipman, D.J.; Ostell, J.; Sayers, E.W. GenBank. Nucleic Acids Res. 2013, 41, D36–D42. [Google Scholar] [CrossRef] [PubMed]
- Adácsi, C.; Kovács, S.; Pócsi, I.; Győri, Z.; Dombrádi, Z.; Pusztahelyi, T. Microbiological and toxicological evaluation of fermented forages. Agriculture 2022, 12, 421. [Google Scholar] [CrossRef]
- Poornachandra Rao, K.; Deepthi, B.V.; Rakesh, S.; Ganesh, T.; Achar, P.; Sreenivasa, M.Y. Antiaflatoxigenic potential of cell-free supernatant from Lactobacillus plantarum MYS44 against Aspergillus parasiticus. Probiotics Antimicro Prot. 2019, 11, 55–64. [Google Scholar] [CrossRef] [PubMed]
- Husain, A.; Hassan, Z.; El-mabrok, A.S.W.; Lani, M.N.; Munir, M.B. In vitro efficacy of lactic acid bacteria with antifungal activity against Fusarium sp. CID124-CS isolate from chilli seeds. Int. J. Sci. Techn. Res. 2017, 6, 128–132. [Google Scholar]
- Christensen, S.; Borrego, E.; Shim, W.B.; Isakeit, T.; Kolomiets, M. Quantification of fungal colonization, sporogenesis, and production of mycotoxins using kernel bioassays. J. Vis. Exp. 2012, 62, 3727. [Google Scholar] [CrossRef]

| LAB Strains | Source | Gram Staining | Catalase Assay | MRS+ CaCO3 | Accession Number * | |
|---|---|---|---|---|---|---|
| FCW4 | Lactiplantibacillus plantarum | Fermented coconut water | + | - | + | MT180563 |
| CB2 | Lactiplantibacillus plantarum | Cabbage | + | - | + | PP784682 |
| SD4 | Limosilactobacillus fermentum | Sourdough | + | - | + | PP535088 |
| Growth Inhibition (%) | DON | ZEA | T2 | FB1 |
| FCW4 | 45.9 ± 2.29 aA | 37 ± 1.5 bB | 27.6 ± 1.7 bC | 28 ± 1.7 bC |
| SD4 | <5 bA | 47.1 ± 3.4 aB | 44.6 ± 2.9 aB | 44.9 ± 2.6 aB |
| CB2 | <5 bA | 33.8 ± 2.8 bB | 28.4 ± 1.9 bC | 25.3 ± 1.8 bC |
| Mycotoxin Reduction (%) | DON | ZEA | T2 | FB1 |
| FCW4 | <15 a | 36.7 ± 2.1 b | <15 a | <15 a |
| SD4 | <15 a | <15 a | <15 a | <15 a |
| CB2 | <15 a | 45.5 ± 3.2 c | <15 a | <15 a |
| Treatments | Kernel | Fungus | LAB | Root (mm) | Shoot (mm) |
|---|---|---|---|---|---|
| 1 | - | - | - | 39.16 ± 9.40 | 7.53 ± 3.73 |
| 2 | cut | - | - | 51.47 ± 10.87 | 10.47 ± 2.65 |
| 3 | - | Fv | - | 49.25 ± 9.66 | 12.29 ± 7.54 |
| 4 | cut | Fv | - | 48.57 ± 14.35 | 15.13 ± 5.76 |
| 5 | cut | Fv | FCW4 | 56.07 ± 10.52 | 11.43 ± 5.09 |
| 6 | cut | Fv | CB2 | 57.27 ± 15.97 | 12.53 ± 5.64 |
| 7 | cut | Fv | SD4 | 62.09 ± 15.19 | 20.45 ± 6.70 |
| Root | Shoot | ||||||
|---|---|---|---|---|---|---|---|
| Treatments | t Stat | t Crit | p | t Stat | t Crit | p | |
| 1 | 2 | −3.7346 | 2.0301 | 0.0007 | −2.8055 | 2.0369 | 0.0085 |
| 2 | 4 | 0.8035 | 2.0141 | 0.4259 | −3.8358 | 2.0154 | 0.0004 |
| 3 | 4 | 0.2140 | 2.0076 | 0.8314 | −1.6086 | 2.0086 | 0.1140 |
| 4 | 5 | −2.3082 | 2.0057 | 0.0249 | 2.6370 | 2.0025 | 0.0108 |
| 4 | 6 | −2.2190 | 2.0025 | 0.0305 | 1.7673 | 2.0017 | 0.0824 |
| 4 | 7 | −2.5633 | 2.1098 | 0.0202 | −2.3370 | 2.1199 | 0.0328 |
| 5 | 6 | −0.3436 | 2.0086 | 0.7326 | −0.7933 | 2.0025 | 0.4309 |
| 5 | 7 | −1.2130 | 2.1448 | 0.2452 | −4.0576 | 2.1448 | 0.0012 |
| 6 | 7 | −0.8886 | 2.0930 | 0.3854 | −3.4944 | 2.1199 | 0.0030 |
| Treatments | pH | Log LAB * | Log Mold * | Mycoflora ** | LA (m/m%) | AA (m/m%) | ZEA (µg/kg) | FUM (mg/kg) | DON (mg/kg) |
|---|---|---|---|---|---|---|---|---|---|
| C | 5.74 ± 0.2 a | 7.342 ± 6.342 a | 6.362 ± 5.361 a | Fusarium | 22.6 ± 3.01 a | 4.12 ± 0.62 a | <0.001 | <0.200 | <0.010 |
| C+SD4 | 6 ± 0.15 a | 8.041 ± 7.380 b | 6.415 ± 5.414 ab | - | 1.98 ± 0.26 b | 1.25 ± 0.19 b | <0.001 | <0.200 | <0.010 |
| C+CB2 | 5.18 ± 0.12 bc | 8.380 ± 4.681 c | 5.415 ± 4.412 c | - | 6.58 ± 0.98 c | 1.68 ± 0.25 bc | <0.001 | <0.200 | <0.010 |
| C+FCW4 | 5.27 ± 0.07 b | 8.041 ± 7.041 b | 6.477 ± 5.477 b | - | 4.45 ± 0.67 d | 3.09 ± 0.46 d | <0.001 | <0.200 | <0.010 |
| C+M | 4.40 ± 0.2 d | 7.662 ± 6.662 d | 6.653 ± 5.653 d | - | 19.77 ± 2.96 ae | 0.930 ± 0.14 e | 23.59 ± 3.53 a | 0.27 ± 0.040 a | 0.012 ± 0.001 a |
| C+M+SD4 | 5.06 ± 0.14 c | 8.519 ± 7.518 c | 4.903 ± 3.903 e | - | 15.18 ± 2.26 e | 1.97 ± 0.29 c | 12.9 ± 1.935 b | 0.360 ± 0.054 a | <0.010 |
| C+M+CB2 | 5.05 ± 0.15 c | 8.431 ± 7.431 c | 6.204 ± 5.204 f | Fusarium | 8.94 ± 1.34 f | 1.44 ± 0.21 bc | 8.33 ± 1.249 c | 0.350 ± 0.052 a | <0.010 |
| C+M+FCW4 | 6.15 ± 0.11 e | 7.672 ± 6.672 d | 6.681 ± 5.681 d | Fusarium | 2.98 ± 0.44 g | 0.890 ± 0.13 e | 20.2 ± 3.03 a | 0.240 ± 0.036 a | 0.013 ± 0.001 a |
Disclaimer/Publisher’s Note: The statements, opinions and data contained in all publications are solely those of the individual author(s) and contributor(s) and not of MDPI and/or the editor(s). MDPI and/or the editor(s) disclaim responsibility for any injury to people or property resulting from any ideas, methods, instructions or products referred to in the content. |
© 2025 by the authors. Licensee MDPI, Basel, Switzerland. This article is an open access article distributed under the terms and conditions of the Creative Commons Attribution (CC BY) license (https://creativecommons.org/licenses/by/4.0/).
Share and Cite
Krishnan, S.V.; Anaswara, P.A.; Nampoothiri, K.M.; Kovács, S.; Adácsi, C.; Szarvas, P.; Király, S.; Pócsi, I.; Pusztahelyi, T. Biocontrol Activity of New Lactic Acid Bacteria Isolates Against Fusaria and Fusarium Mycotoxins. Toxins 2025, 17, 68. https://doi.org/10.3390/toxins17020068
Krishnan SV, Anaswara PA, Nampoothiri KM, Kovács S, Adácsi C, Szarvas P, Király S, Pócsi I, Pusztahelyi T. Biocontrol Activity of New Lactic Acid Bacteria Isolates Against Fusaria and Fusarium Mycotoxins. Toxins. 2025; 17(2):68. https://doi.org/10.3390/toxins17020068
Chicago/Turabian StyleKrishnan, S. Vipin, P. A. Anaswara, K. Madhavan Nampoothiri, Szilvia Kovács, Cintia Adácsi, Pál Szarvas, Szabina Király, István Pócsi, and Tünde Pusztahelyi. 2025. "Biocontrol Activity of New Lactic Acid Bacteria Isolates Against Fusaria and Fusarium Mycotoxins" Toxins 17, no. 2: 68. https://doi.org/10.3390/toxins17020068
APA StyleKrishnan, S. V., Anaswara, P. A., Nampoothiri, K. M., Kovács, S., Adácsi, C., Szarvas, P., Király, S., Pócsi, I., & Pusztahelyi, T. (2025). Biocontrol Activity of New Lactic Acid Bacteria Isolates Against Fusaria and Fusarium Mycotoxins. Toxins, 17(2), 68. https://doi.org/10.3390/toxins17020068

